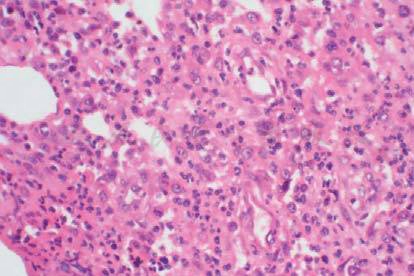

病情介绍
患者,男,35岁,因“咳嗽、发热2月余”于2008年3月28日入院 。患者于2008年1月下旬无明显诱因下出现咳嗽,伴咳少量白色黏痰,易咳出,时有发热(体温不详),伴有乏力、纳差、盗汗,无胸痛、胸闷、气促和呼吸困难,咳嗽剧烈时偶有背部疼痛,不伴恶心、呕吐、腹痛、腹泻和尿频、尿急、尿痛等症状,当地医院CT提示“肺内多处斑片样渗出病灶,并有肺门纵隔淋巴结肿大”,诊断为“肺部感染,淋巴结肿大原因待查(结核?淋巴瘤?)”。浅表淋巴结活检病理提示“炎症性改变”,给予抗感染和抗结核治疗,具体方案不详,未见好转,并出现咳血丝痰2次,转来我院。发病以来皮肤黏膜未出现红肿和破溃,无意识和人格改变,精神、睡眠尚可,食欲欠佳,体重减轻2kg。2006年曾患结核性脑膜炎,不规则抗结核3个月后停药,否认重大外伤、手术史,否认食物药物过敏史,无输血史。无外地长期居住史,无疫禽、疫水接触史,无烟酒嗜好,否认冶游史。父亲5年前死于白血病,余无特殊。
入院查体
T 37℃,P 90次/分,R 20次/分,BP 124/76mmHg。一般情况尚可,皮肤黏膜无皮疹,左腹股沟可触及两个花生米大小肿大淋巴结,质韧,无压痛,活动尚可,表面无红肿和破溃,颈无抵抗。胸廓无畸形,皮下无气肿,双肺少许湿
啰音,心率92次/分,律齐,未闻及杂音及心包摩擦音。腹部平坦,未见肠型及蠕动波,腹肌无紧张,全腹无压痛、反跳痛,肝脾肋下未及,肝肾区无叩击痛,Murphy征阴性,移动浊音阴性。髌骨以下凹陷性水肿,伴有皮温升高,未见杵状指(趾),神经系统阴性。化验:WBC 25.9×109/L,N 73.7%,Hb 92g/L,PLT 56×109/L;ALB 22.6g/L,K+ 3.25mmol/L,Na+ 135.1mmol/L,Glu 4.2mmol/L;尿、便常规正常;肾功能正常;HIV抗体阴性,淋巴细胞亚群正常;骨穿细胞学检查:反应性骨髓象,粒系为主,红系降低;痰多次找抗酸杆菌,细菌和真菌培养均阴性;胸部CT(2008-4-7)示左肺上叶、舌叶及下叶背段炎症,肺门、纵隔多发淋巴结肿大(图1)。
图1 2008-4-7胸部CT
a.左肺上叶、舌叶及下叶背段炎症;b.肺门、纵隔多发淋巴结肿大
入院诊断
①左肺炎;②多重耐药结核病;③侵袭性真菌病;④淋巴瘤。
住院期间从3月底到4月底经常有发热,体温在37~40℃之间。2008年4月25日B超提示肝脾大,胆胰及腹主动脉旁未见异常。2008年5月9日B超提示双侧胸腔少量积液。胸腔积液检查:Glu 5.68mmol/L,LDH 359U/L,总蛋白56.2g/L,ADA 6.0U/L;李凡他:(+/–)有核细胞:1080×106/L,多核50%,淋巴细胞40%,间皮细胞10%。胸腔积液中未找到癌细胞。4月底5月初左上臂和右大腿内侧出现皮肤结节并逐渐形成脓疱,做组织活检并抽取脓液培养,皮下结节组织病理报告:毛细血管和成纤维细胞增生,各种炎细胞(包括中性粒细胞、巨噬细胞、浆细胞)浸润,形成脓肿膜,病变呈软组织慢性化脓性炎症改变(图2)。PAS染色见可疑真菌(图3)。 脓液培养与鉴定结果:分离培养出马内菲青霉(图4,5)。
图2 皮下结节病理示毛细血管和成纤维细胞增生,各种炎细胞(包括中性粒细胞、巨噬细胞、浆细胞)浸润,形成脓肿膜,病变呈软组织慢性化脓性炎症改变(HE×200)

图3 a图病变中散在少量红染酵母样异物,可疑真菌,但形态与典型马内菲青霉有差距,未见诊断性菌体特征;b图为典型马内菲青霉体(PAS染色×400)

图4 脓液培养与鉴定结果:接种于沙保罗培养基,分别置于25℃和37℃孵育,分离培养出马内菲青霉(于37℃孵育为酵母相 ,无色素产生,于25℃孵育为青霉相 ,产生具有特征性的红色色素)

图5 镜下可见典型的帚状枝菌丝以及孢子链特征性表现(乳酸棉酚蓝染色×1000)
最终诊断
马内菲青霉病。
重要提示
1.青年男性,慢性起病,以咳嗽、咳痰,乏力,纳差,盗汗,反复发热为主要症状,伴有浅表和肺门纵隔淋巴结肿大;
2.随病情进展,逐渐出现其他组织器官的侵犯,如皮肤结节和脓疱,肝脾大,胸腔积液等;
3.既往有结核病史,未正规抗结核;
4.外周血白细胞增高,中性分类增高,并有轻度贫血;
5.胸部CT:肺内多处斑片样渗出病灶,并有肺门纵隔淋巴结肿大;
6.病理检查为慢性化脓性炎症改变,PAS染色见可疑真菌;
7.皮肤脓液分离培养出马内菲青霉;
8.普通抗生素和抗结核治疗无效,抗真菌治疗后逐渐好转。
在未得到病原学和病理学诊断前按一般感染治疗给予头孢呋辛、克林霉素、头孢哌酮/舒巴坦、氟罗沙星等治疗2周后临床未见明显改善,后考虑为结核杆菌感染,给予HREZ方案抗结核2周亦未见缓解。4月底根据病理和病原学结果,先给予伏立康唑 0.2g b.i.d静脉滴注治疗,7天后患者症状开始有改善,但仍有低热,2周后改为两性霉素B脂质体100mg q.d静脉滴注,9天后因药物反应和费用问题,再改为氟康唑0.4g q.d静脉滴注共29天,体温五月中旬后恢复正常,症状继续好转,血白细胞等复查正常,胸部CT提示肺炎症治疗后明显吸收好转,肺门及纵隔多发淋巴结肿大有所缩小(图6)。

图6 2008-6-12肺CT复查
a.左肺上叶、舌叶及下叶背段炎症治疗后明显吸收好转,右胸膜轻度粘连肥厚;b.肺门及纵隔多发淋巴结肿大有所缩小
1.杨敬芳,李继红.马内菲青霉病的研究进展.国外医学临床生物化学与检验学分册,2004,25(1):45-47
2.Deng ZL,Conner DH.Progressive Penicilliosis becaused by penicimarneffei:Report of 8 cases and differentiation of the causationo organism from histoplasm. Am J Clin Pathol,1985,3:323-327
3.黄长武,李兴禄,黄艺,等.马内菲青霉的鉴定,微生物学杂志, 2006,26(1):61-65
4.李云,李雪梅,陈燕. 马内菲青霉病的真菌培养与鉴定.实用医学杂志,2004,20(5):582-583
5.王文娟,梁伶.深部真菌感染治疗和耐药的研究进展.医学综述,2008,14(5):762-764